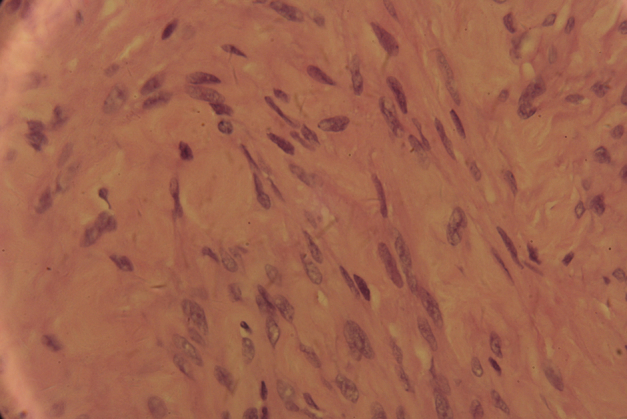
Figure 4

Abstract
Leiomyomas are common benign tumors in the uterus. They are rarely seen in the vaginal wall leading to pressure symptoms on urinary tract. Here we present a case of a 44-year-old Chinese woman, who had accepted hysterectomy, with a painless paraurethral mass associated with local discomfort. A complete surgical excision was performed by vaginal route, and the histology report confirmed the diagnosis of benign leiomyoma.
Keywords: Misdiagnose, Paraurethral mass, Vaginal leiomyoma, Surgery
Introduction
Leiomyomas of the vagina are very rare; approximately 300 cases have been reported in the literature so far.1 These fibromyomas usually arise from the anterior vaginal wall. Depending on the size and location, vaginal leiomyomas may cause varied clinical presentations, such as dyspareunia, pain, or dysuria.2 Here we are reporting a case which was misdiagnosed as paraurethral cyst preoperatively but was confirmed by the histopathologic study.
Case report
A 44-year-old gravida 1, para 1 woman was referred to the outpatient department in June 2013 for a protruding mass at the urethral opening, which had caused discomfort for 1 year. The patient had one cesarean section delivery and had undergone abdominal hysterectomy 4 years ago because of uterus myoma.
On examination, a round, cystic, non-tender mass, measuring approximately 3–4 cm in diameter, was palpable between the urinary meatus and the vaginal orifice.
Magnetic resonance imaging (MRI) revealed the presence of a 3 × 4 × 3 cm mass which displaced the urethra laterally. The mass showed a slightly heterogenous low signal intensity on the T2-weighted images (Fig. 1). The mass displayed uniform enhancement with gadolinium administration (Fig. 2).
Figure 1.

MRI showed a mass arising from anterior wall of the vagina.
Figure 2.

MRI showed uniform enhancement after gadolinium administration on T2-weighed images.
Because of the location and image findings, a paraurethral cyst was considered the likely diagnosis. We decided to perform surgical excision through the vaginal route. A Foley's catheter was introduced in the urethra for protecting the latter during the operation. After making a midline incision on the anterior vaginal wall, we found a 3 cm soft tumor with a capsule in the vaginal wall. And there was no evidence of any connection between the tumor and the urethra. The mass was removed completely and sent for frozen-pathology, which reported leiomyoma. The vagina was repaired by the two-layer closure procedure.
The patient was discharged on postoperative day 4. Histology of the paraffin specimen confirmed the diagnosis of a benign leiomyoma (Figure 3, Figure 4).
Figure 3.

Tumor showing dense aggregation of spindle-shaped cells (HE ×100).
Figure 4.
Histopathological appearance confirming leiomyoma (HE ×400).
Discussion
Vaginal leiomyomata are benign mesenchymal tumors of the vaginal wall that arise from smooth muscle elements. They are uncommon. In a recent series of 79 patients with periurethral masses, 4 (5%) were found to have vaginal leiomyoma.3 These masses may occur anywhere within the vagina and vary from 0.5–15 cm in diameter. They commonly present as a smooth, firm, round mass on the anterior vaginal wall. Sometimes, they may be misdiagnosed as urethral diverticulum or paraurethral cyst.3
Vaginal leiomyomas usually develop in women between the ages of 35 and 50.2 Usually the tumor is single, and most are small and slow growing. But these lesions are usually estrogen dependent and can grow rapidly during pregnancy or regress after menopause. They can be asymptomatic or present with symptoms related to the size and location of the lesion. Symptoms include a mass effect, obstruction, pain, and dyspareunia.2
Before surgical intervention, ultrasound and MRI may help to estimate the extent, characterization and involvement of the mass.4 Excision or enucleation through a vaginal approach is often curative and is recommended to confirm the diagnosis, to exclude malignant histology, and also to alleviate symptoms. In case of large tumors, however, an abdomino-perineal approach is preferred.
In this case, we had considered the possible diagnosis of paraurethral mass preoperatively. However the pathology corrected our diagnostic error. Although the patient had accepted hysterectomy, the rest vagina also had a chance to develop leiomyomas. Other report confirmed it.5 The transvaginal ultrasound-guided needle biopsy maybe help to enhance the diagnosis accuracy before surgery. Our patient was symptom free for a 1-year follow-up.
Conflict of interest
The authors declare they have no conflict of interest.
Acknowledgment
The authors acknowledge the patient for consenting to reveal the case details and photographs for publication.
Footnotes
Available online 18 March 2015
Dr. Yu Wu and Dr. Weiming Wang contributed equally to this work.
References
- 1.Chakrabarti I., De A., Pati S. Vaginal leiomyoma. J Midlife Health. 2011;2(1):42–43. doi: 10.4103/0976-7800.83274. [DOI] [PMC free article] [PubMed] [Google Scholar]
- 2.Costantini E., Cochetti G., Porena M. Vaginal para-urethral myxoid leiomyoma: case report and review of the literature. Int Urogynecol J Pelvic Floor Dysfunct. 2008;19(8):1183–1185. doi: 10.1007/s00192-008-0588-9. [DOI] [PubMed] [Google Scholar]
- 3.Blaivas J.G., Flisser A.J., Bleustein C.B., Panagopoulos G. Periurethral masses: etiology and diagnosis in a large series of women. Obstet Gynecol. 2004;103(5 Pt 1):842–847. doi: 10.1097/01.AOG.0000124848.63750.e6. [DOI] [PubMed] [Google Scholar]
- 4.Sherer D.M., Cheung W., Gorelick C. Sonographic and magnetic resonance imaging findings of an isolated vaginal leiomyoma. J Ultrasound Med. 2007;26(10):1453–1456. doi: 10.7863/jum.2007.26.10.1453. [DOI] [PubMed] [Google Scholar]
- 5.Yogesh K., Amita M., Rajendra K. Vaginal leiomyoma developing after hysterectomy – case report and literature review. Aust N Z J Obstet Gynaecol. 2005;45(1):96–97. doi: 10.1111/j.1479-828X.2005.00354.x. [DOI] [PubMed] [Google Scholar]
